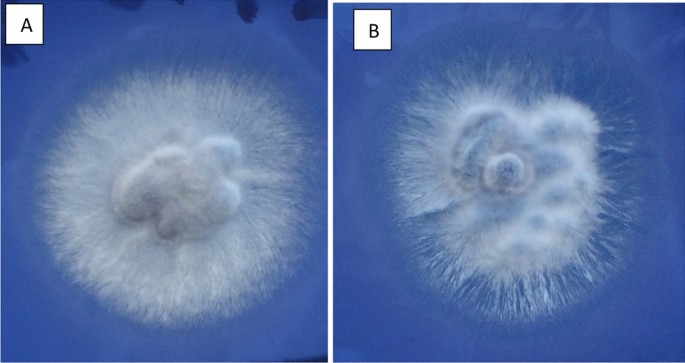

- Case Report
- Open access
- Published:
Oral isolation of Geotrichum silvicola with Geotrichum candidum from immunocompetent teenager with oral Geotrichosis signs: the first documented case report
Bulletin of the National Research Centre volume 47, Article number: 148 (2023)
Abstract
Background
Oral geotrichosis is an infection caused by Geotrichum species. It is an uncommon opportunistic oral fungal infection caused mainly by Geotrichum candidum and rarely found in immunocompetent hosts. This report attempted to highlight a case of unusual geotrichosis, which requires accurate observation, as well as indicate the appropriate diagnostic methods that may contribute to eliminating the misdiagnosis of this fungal infection.
Case presentation
We report of unusual isolation of Geotrichum silvicola and Geotrichum candidum from the oral cavity of a 15-year-old immunocompetent female with a sign of oral geotrichosis. The isolation of Geotrichum silvicola and Geotrichum candidum was performed using Mitis Salivarius Agar. After a month of prescribing appropriate medication and improving oral hygiene, the patient showed the absence of all the signs of geotrichosis without any complaints and an improvement in overall oral health.
Conclusions
The isolation of Geotrichum silvicola and Geotrichum candidum from the oral cavity of an immunocompetent patient is considered an unusual and rare case that documented for the first time.
Background
Geotrichum species are arthroconidial yeasts belonging to the Endomycetales family of the Ascomycota phylum. They are yeast-like fungi since their colonies are similar to yeast, producing arthroconidia and absence of blastoconidia (Kamilari et al. 2023).
Infections caused by Geotrichum species are known as geotrichosis. It is an opportunistic and uncommon mycoses infection that, in most cases, infects individuals with compromised immune systems, such as diabetics, immunodeficiency syndrome patients, organ transplant patients, and haematological malignant patients (Bonifaz et al. 2010; Heinic et al. 1992; Tshisevhe et al. 2021; Kangül et al. 2020; Rajme-López et al. 2022).
Among Geotrichum species, the yeast Geotrichum candidum is thought to be the most common cause of Geotrichosis (Bose and Brizuela 2023; Pal et al. 2013; Garza et al. 2018).
Geotrichum candidum is emerging as an opportunistic pathogen that can produce disease in humans. This organism was reported to be responsible for frequent pulmonary cases as well as oral, bronchial, vaginal, cutaneous, and other human organs (Keene et al. 2019).
Oral geotrichosis, as with all opportunistic fungal infections of the oral cavity, is frequently diagnosed in immunocompromised patients and rarely in immunocompetent hosts (Pal et al. 2013; Farzanegan et al. 2021).
Clinical features of oral geotrichosis are similar to those of oral candidiasis and have been described in three clinical appearances (pseudomembranous, hyperplastic, and ulcerative).
It is a superficial fungal infection with a chronic inflammatory response in the underlying connective tissue (Bonifaz et al. 2010; Shah et al. 2021).
Geotrichum silvicola, which is one of the species that make up the genus Geotrichum, was first reported in 2005 and described as a species that belongs to a clade of several Galactomyces species (Pimenta et al. 2005). To our knowledge, no documentation has established a correlation between G. silvicola and oral geotrichosis, nor has it been isolated with G. candidum from the oral cavity of the same patient. We thus document for the first time the isolation of G. silvicola and G. candidum from the mouth of immunocompetent patient presenting signs of oral geotrichosis.
Case presentation
This study was conducted in the Department of Dentistry and Orthodontics at Uşak University and was based on the enumeration of streptococcal species in saliva samples from 50 patients prior to orthodontic treatment. During the first phase of the study, panoramic X-rays were performed for all patients. Additionally, morning blood and saliva samples were collected from all patients prior to the start of orthodontic treatment. Patients' blood samples were processed, and a complete blood count was conducted to assess any signs referring to abnormal levels in the blood. Before the collection of saliva samples, sterile container was given to the patient. While the patient was sitting with his head tilted forward in a quiet environment, the saliva accumulated in the mouth was requested to be poured into the sterile container. The patients were instructed to clean their oral cavity with three clean-water oral washes prior to obtaining the saliva. After that, all saliva samples collected in sterile containers were sent to the Vocational School of Health Services Department of Medical Services and Techniques Medical Laboratory. 100 μl of saliva from each patient was inoculated and spread with sterile cotton swabs on Mitis Salivarius Agar (Liofilchem, Roseto degli Abruzzi TE, Italy), which was prepared without adding potassium tellurite and incubated at 37 °C. After two days of incubation, the culture results revealed an unusual condition that was detected in a 15-year-old female patient. The culture of this patient showed the apparent growth of two different fungal colonies (Fig. 1). Microscopic examination of both colonies revealed typical septate hyphae that broke to produce chains of hyaline arthroconidia. The arthroconidal appearance took different forms, such as barrel-shaped, rectangular, or cylindrical, which is round at the ends (Fig. 2).
Microscopic examination of Geotrichum sivicola and Geotrichum candidum colonies after 1 week of growth on Mitis Salivarius Agar. A1and A2 photos show hyphae and arthrospores of Geotrichum sivicola. The hyphae are septate, and the arthroconidia are hyaline and of elongated rectangular form. Photos B1and B2 show hyphae and arthrospores of Geotrichum candidum. The hyphae are hyaline with a typical septate. Fertile hypha are fragmented to produce slightly inflating arthroconidia with different shapes ranging from rounded to cylindrical (barrel-shaped or rounded at the ends). Magnification × 400
A subculture from the initial growth was performed on Mitis Salivarius Agar without adding potassium tellurite and revealed two types of dry white fungal colonies after 72 h at room temperature (Fig. 3). The morphology of the two colonies was difficult to distinguish and appeared as dry, buttery colonies that emulsified when touched with a microbiological loop, which is an important clue that indicates Geotrichum species. The MALDI-TOF test and molecular identification results confirmed the two isolates as G. silvicola and G. candidum (Abed et al. 2023).
After the unexpected results of the microbiological examination, a careful intraoral examination was carried out for the patient. The intraoral examination revealed creamy, whitish-yellow patches, like a pseudomembranous appearance, in the buccal mucosa of the right and left cheeks (Fig. 4). An oral swab was taken from the sites of the lesion after the patient was instructed to clean her oral cavity with three clean-water oral washes and examined under the microscope. Careful examination revealed the fungal structure of a chain of arthroconidia that formed septate hyphae (Fig. 4).
Intraoral examination revealed a creamy, yellow-whitish, pseudomembranous patch in the buccal mucosa of the right (A) and left (B) cheeks of the patient. C Microscopic examination of the oral swab from the sites of lesion revealed fungal structure of a chain of arthroconidia that formed septate hyphae (black arrows)
A frontal view of the panoramic X-ray, which was taken synchronously with saliva collection, showed an obvious narrowing of the air passages and deviation of the nasal septum, with clear radiolucency of the sinus on the right side. These results can provide evidence of fluid in the sinus or a thickened mucous membrane, which is a strong affirmation of a sinus infection (Fig. 5). Oral pseudomembranous and radiographic results were consistent with microbiological results and strongly confirmed oral geotrichosis due to Geotrichum species. The results of the blood test indicated that the complete blood count and white blood cell count were all at normal levels. In the anamnesis taken from the patient, it was learned that there were mouth sores approximately three months prior, which may refer to the patient's lack of interest in maintaining dental good hygiene and could account for the flourishing of this type of opportunistic fungi. She had no chronic, immunological, genetic, haematological, malignant, or other conditions in her medical history and had never had an operation or COVID-19. There was no history of antibiotic use or smoking. She did not complain about her mouth during the saliva sampling. The patient complained only of headaches and pain at sinus sites that supported radiographic observations. The patient was diagnosed as immunocompetent with oral geotrichosis caused by G. silvicola and G. candidum. Miconazole mouth gel for two weeks and two types of fluoride-free toothpaste twice a day were prescribed, and the patient was advised to care for oral hygiene. After a month, the patient was called to an observation session, which showed the absence of all the signs of geotrichosis without any complaints of headache, pain in the mouth or in the sinus sites, and improvement in overall oral health. Laboratory and radiology investigation revealed total cure of oral infection.
A panoramic x-ray, frontal view, shows an abnormality in the vaults of the right sinus. The image shows a noticeable narrowing of the air passages and a deviation of the nasal septum. There is also clear radiolucence of the sinus on the right side (white arrow), which may indicate a thickening of the sinus wall and fluid inside the sinus
Discussion
Geotrichum species have been reported as an upper respiratory and gastrointestinal tract inhabitants in 30% of healthy people, and the isolation of this fungus from skin and sputum samples taken from healthy individuals is not uncommon (Heinic et al. 1992).
However, another report indicated that G. candidum may be part of the normal flora of the oral cavity or found as a contaminant. The report concluded that the infection caused by this fungus is probably endogenous, making it similar to the infection caused by Candida spp. (Bonifaz et al. 2010). Depending on organ involvement, geotrichosis is classified into pulmonary, bronchial, intestinal, cutaneous, or mucosal (oral) types and usually occurs in immunocompromised individuals (Rajendra Santosh et al. 2021).
Oral geotrichosis clinically mimics the oral pseudomembranous associated with Candida spp. (Shah et al. 2021; Rajendra Santosh et al. 2021).
The pseudomembranous sign is found in 75% of patients with oral geotrichosis, and the symptoms appear as creamy-white pseudomembranous patches with an erythematous background on the tongue, and on the cheeks (Bonifaz et al. 2010).
These results are consistent with the pseudomembranous found in our patient which was resembled oral candidiasis. The lesion was whitish to creamy, and could be easily removed with a cotton swab, leaving an erythematous mucosa surface. It was located as patches on the buccal mucosa of the cheeks. The X-ray findings of our patient revealed an obvious sign of sinusitis, which is strong evidence that supports the presence of geotrichosis.
Cases of fungal sinusitis have increased over the past several years. Dematiaceae and Aspergillus families of fungi are frequently identified as causative agents in these cases (Marglani and Shaikh 2015).
These types of sinusitis have been divided into invasive and noninvasive types. Noninvasive types occur in the forms of fungal infestation, allergic fungal sinusitis and fungal ball (Deutsch et al. 2019).
Allergic fungal sinusitis appears as a form of rhinosinusitis in immune-competent atopic people. It is frequently found in young individuals, with a mean age of approximately 21 years (Mohammadi et al. 2017).
Patients with allergic fungal sinusitis usually suffer from several symptoms, ranging from chronic sinusitis to headache. Although pain is a rare sign, seven patients who made up a percentage of (26%) in one survey complained of headaches, eyesore, and facial pain. In the same survey, of 27 cases of fungal sinusitis, two were found to be caused by G. candidum. The two cases were female; one was diabetic, and the other had no predisposing factors and complained of nasal congestion (Mohammadi et al. 2017). In our study, the patient reported headaches and facial pain that were consistent with the results of the previous survey. Another study isolated G. candidum from a 45-year-old woman diagnosed with diabetes mellitus and hypertension and reported rhinosinusitis (Benachinmardi et al. 2020). Until a few years ago, Geotrichum species had not been relevant as pathological agents. However, opportunistic infections caused by these fungi have begun to increase due to the increasing number of immunocompromised people (Vaux et al. 2014).
Patients with predisposing factors such as tuberculosis, diabetes, lymphoma, leukemia, Human Immunodeficiency Virus, and immunosuppressive therapy are the target of G. candidum, which causes opportunistic infections in these individuals. Most infections caused by this fungus occur in adults, and women are slightly more frequently affected (Bonifaz et al. 2010; Sfakianakis et al. 2007). Although geotrichosis is rarely observed in immunocompetent hosts, one study reported a case of urinary tract infection due to G. candidum in a young immunocompetent female patient after catheterization (Shinde et al. 2015). The severity of the clinical feature was found to be lower in immunocompetent patients and seldom reported (Zein et al. 2020). The patient in our study was a 15-year-old woman and immunocompetent individual who complained of non-serious oral geotrichosis. To our knowledge, this may be considered a very rare occurrence that has not been reported before. Regarding G. silvicola, which was first described in a report published in 2005, we found two Chinese case reports published in 2004 and 2006 that indicated the isolation of G. silvicola. The first case was in a 9-year-old boy who had a kerion-form lesion on his scalp, and the second case was of toxic epidermal necrolysis associated with geotrichosis due to G. silvicola (Li et al. 2004; Gao et al. 2006).
However, there are no published reports indicating that G. silvicola is isolated from the mouth. In our case, we reported for the first time the isolation of this fungus orally from a patient complaining of geotrichosis, which is also a very rare case that was documented for the first time. The isolation of G. silvicola and G. candidum at the same time from the oral cavity of the immunocompetent patient is reported for the first time in our study. The isolation of G. silvicola and G. candidum was performed in our study on Mitis Salivarius Agar. According to the technical data sheet of LIOFILCHEM, this medium is manufactured and designed with supplements for the selective isolation of viridans streptococci and enterococci from specimens containing mixed microbial flora (LIOFILCHEM 2016). We discovered that without adding potassium tellurite G. silvicola and G. candidum were successfully cultured and gave diagnostic morphology on this medium. These results could open the door to further studies to experiment this medium for testing and comparison with classic means, such as Sabouraud and Mycosel agar, for the isolation of the main fungal pathogens that can affect the oral cavity, such as Candida, Histoplasma and Paracoccidioides.
Conclusions
Reports about Geotrichum species as etiological agents among immunocompromised patients have been increasing in recent years. We believe that misreporting or misdiagnosis with other species, like Candida, could be the reason it is rarely reported. An earlier study also suggested this rationale (Kassamali et al. 1987). Further studies of this fungus are essential to determine if it is present in the mouth as normal flora or as a contaminant. In addition, study the possibility of immunocompetent individuals being infected with this fungus and whether minor disorders in those individuals turn this fungus into an opportunist. More importantly, we think it's critical that dentists, microbiologists, and radiography specialists collaborate and conduct a complete examination in order to diagnose this type of opportunistic infection. Moreover, the choice of the appropriate medium and the cultivation of this fungus under appropriate conditions, as well as the use of molecular analysis, can contribute to the successful isolation of these species and make a final diagnosis to eliminate the misdiagnosis.
Availability of data and materials
Not applicable.
References
Abed AB, Hürkan K, Ünal A et al (2023) Phenotypic and molecular genetics study of Geotrichum candidum Link (1809) and Geotrichum silvicola Pimenta (2005) cultivated on mitis salivarius agar. Mol Biol Rep 50:6049–6061. https://doi.org/10.1007/s11033-023-08443-z
Benachinmardi K, Sangeetha S, Rudramurthy S (2020) Fungal rhinosinusitis by Geotrichum candidum. Int J Health Allied Sci 9(3):287–289
Bonifaz A, Vázquez-González D, Macías B, Paredes-Farrera F, Hernández MA, Araiza J et al (2010) Oral geotrichosis: report of 12 cases. J Oral Sci 52(3):477–483. https://doi.org/10.2334/josnusd.52.477
Bose D, Brizuela M (2023) Fungal infections of the oral mucosa. In: StatPearls [Internet]. StatPearls Publishing, Treasure Island
Deutsch PG, Whittaker J, Prasad S (2019) Invasive and non-invasive fungal rhinosinusitis: a review and update of the evidence. Medicina (Kaunas) 55(7):319. https://doi.org/10.3390/medicina55070319
El Zein S, Hindy JR, Kanj SS (2020) Invasive Saprochaete infections: an emerging threat to immunocompromised patients. Pathogens 9(11):922. https://doi.org/10.3390/pathogens9110922
Farzanegan A, Khalandi H, Falahati M, Khoozestani PK (2021) Fungi associated oral cavity hygiene and denture stomatitis: a review on diagnostic and treatment. J Curr Biomed Rep 2(4):150–158
Gao S, Zhu J, Lin Y, Tang X, Kang R (2006) A case report of toxic epidermal necrolysis associated with geotrichosis due to Geotrichum silvicola. Chin J Dermatol 39(11):648–650
Garza JR, Miranda RS, Garza AM, Texis AP, Díaz EG, Juárez US (2018) Peritonitis due to Geotrichum candidum in continuous ambulatory peritoneal dialysis. Case Rep Clin Med 7(3):232–240. https://doi.org/10.4236/crcm.2018.73021
Heinic GS, Greenspan D, MacPhail LA, Greenspan JS (1992) Oral Geotrichum candidum infection associated with HIV infection. A case report. Oral Surg Oral Med Oral Pathol 73(6):726–728. https://doi.org/10.1016/0030-4220(92)90019-m
Kamilari E, Stanton C, Reen FJ, Ross RP (2023) Uncovering the biotechnological importance of Geotrichum candidum. Foods 12(6):1124. https://doi.org/10.3390/foods12061124
Kangül H, Özcan N, Uzuner N, Mete M, Mert EU (2020) Saprochaete clavata (Geotrichum clavatum) septicemia in a patient with multiple myeloma; an emerging case from Southeastern Turkey. Curr Med Mycol 6(4):66–69. https://doi.org/10.18502/cmm.6.4.5440
Kassamali H, Anaissie E, Ro J, Rolston K, Kantarjian H, Fainstein V et al (1987) Disseminated Geotrichum candidum infection. J Clin Microbiol 25(9):1782–1783. https://doi.org/10.1128/jcm.25.9.1782-1783.1987
Keene S, Sarao MS, McDonald PJ, Veltman J (2019) Cutaneous geotrichosis due to Geotrichum candidum in a burn patient. Access Microbiol 1(1):e000001. https://doi.org/10.1099/acmi.0.000001
Li X, Zhu J, Lin Y, Gao S, Bai F (2004) Kerion caused by Geotrichum in China: first case report in China. Chin J Dermatol 37(8):446–448
LIOFILCHEM (2016) Mitis Salivarius Agar. TECHNICAL SHEET, TS 611020, Rev.0/06.09.2016.Page 1 of 2. http://www.liofilchem.net/login/pd/ts/611020_TS.pdf
Marglani O, Shaikh AM (2015) Allergic fungal sinusitis eroding the pterygoid plates: a rare case series. Braz J Otorhinolaryngol 81(1):109–112. https://doi.org/10.1016/j.bjorl.2014.05.028
Mohammadi A, Hashemi SM, Abtahi SH, Lajevardi SM, Kianipour S, Mohammadi R (2017) An investigation on non-invasive fungal sinusitis; molecular identification of etiologic agents. J Res Med Sci 22:67. https://doi.org/10.4103/jrms.JRMS_166_17
Pal M, Sejra S, Sejra A, Tesfaye S (2013) Geotrichosis: an opportunistic mycosis of humans and animals. Int J Livest Res 3(2):38–44
Pimenta RS, Alves PDD, Corrêa A, Lachance MA, Prasad GS, Rajaram et al (2005) Geotrichum silvicola sp. nov., a novel asexual arthroconidial yeast species related to the genus Galactomyces. Int J Syst Evol Microbiol 55(Pt 1):497–501. https://doi.org/10.1099/ijs.0.63187-0
Rajendra Santosh AB, Muddana K, Bakki SR (2021) Fungal infections of oral cavity: diagnosis, management, and association with COVID-19. SN Compr Clin Med 3(6):1373–1384. https://doi.org/10.1007/s42399-021-00873-9
Rajme-López S, González-Lara MF, Martínez-Gamboa RA, Rangel-Cordero A, Ponce-de-León A (2022) Geotrichum spp.: an overlooked and fatal etiologic agent in immunocompromised patients. A case series from a referral center in Mexico. Med Mycol 60(4):022. https://doi.org/10.1093/mmy/myac022
Sfakianakis A, Krasagakis K, Stefanidou M, Maraki S, Koutsopoulos A, Kofteridis D et al (2007) Invasive cutaneous infection with Geotrichum candidum: sequential treatment with amphotericin B and voriconazole. Med Mycol 45(1):81–84. https://doi.org/10.1080/13693780600939948
Shah S, Kaur M, Sangeeta G (2021) A review of fungal infections of oral cavity and its emerging trends. Glob J Res Anal. https://doi.org/10.36106/gjra/9114967
Shinde R, Walvekar R, Jhaneshwara K, Mantur B (2015) Urinary tract infection: a very rare presentation of Geotrichum candidum infection. Ann Trop Med Public Health 8(5):212–213. https://doi.org/10.4103/1755-6783.162673
Tshisevhe V, Mitton B, Skosana L (2021) Invasive Geotrichum klebahnii fungal infection: a case report. Access Microbiol 3(11):000287. https://doi.org/10.1099/acmi.0.000287
Vaux S, Criscuolo A, Desnos-Ollivier M, Diancourt L, Tarnaud C, Vandenbogaert M et al (2014) Multicenter outbreak of infections by Saprochaete clavata, an unrecognized opportunistic fungal pathogen. mBio 5(6):e02309-14. https://doi.org/10.1128/mBio.02309-14
Acknowledgements
Not applicable.
Funding
The authors have no relevant financial or non-financial interests to disclose. This research did not receive any specific grant from funding agencies in the public, commercial, or not-for-profit sectors.
Author information
Authors and Affiliations
Contributions
ABA and SEK contributed to: Methodology, Investigation, Visualization, Writing, and Review and Editing. ST contributed to: Conceptualization, Project administration, Methodology, Investigation, and Review and Editing. SG Contributed to: Investigation, Supervision, Review and Editing. IEG contributed to: Conceptualization, Project administration and Review and Editing. All authors have read and approved the manuscript.
Corresponding author
Ethics declarations
Ethics approval and consent to participate
This study was performed in line with the principles of the Declaration of Helsinki. The case was a part of an approved study Project Numbered: 2021/SB001 and approved by the Ethics Committee of Istanbul University with the Decision Numbered: KOEK20-002. Informed consent was obtained from the whole participants in this study project.
Consent for publication
Informed consent was obtained from the whole participants in this study project including the patient.
Competing interests
The authors of this paper declare that there are no competing interests.
Additional information
Publisher's Note
Springer Nature remains neutral with regard to jurisdictional claims in published maps and institutional affiliations.
Rights and permissions
Open Access This article is licensed under a Creative Commons Attribution 4.0 International License, which permits use, sharing, adaptation, distribution and reproduction in any medium or format, as long as you give appropriate credit to the original author(s) and the source, provide a link to the Creative Commons licence, and indicate if changes were made. The images or other third party material in this article are included in the article's Creative Commons licence, unless indicated otherwise in a credit line to the material. If material is not included in the article's Creative Commons licence and your intended use is not permitted by statutory regulation or exceeds the permitted use, you will need to obtain permission directly from the copyright holder. To view a copy of this licence, visit http://creativecommons.org/licenses/by/4.0/.
About this article
Cite this article
Abed, A.B., Korcan, S.E., Titiz, S. et al. Oral isolation of Geotrichum silvicola with Geotrichum candidum from immunocompetent teenager with oral Geotrichosis signs: the first documented case report. Bull Natl Res Cent 47, 148 (2023). https://doi.org/10.1186/s42269-023-01128-4
Received:
Accepted:
Published:
DOI: https://doi.org/10.1186/s42269-023-01128-4